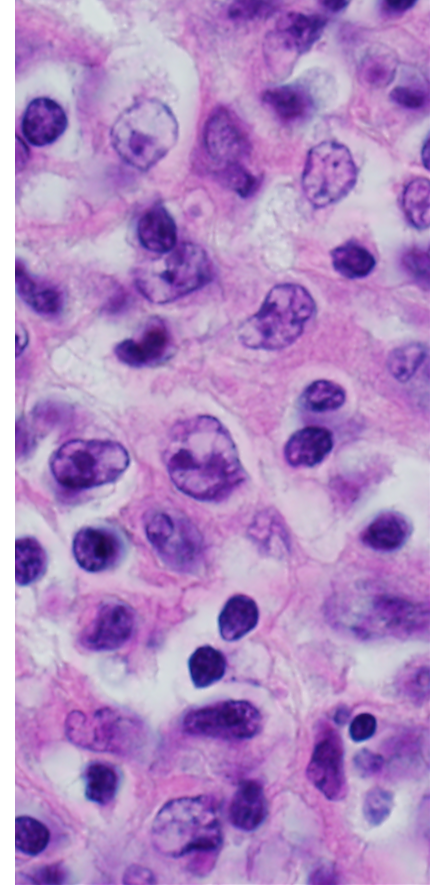
Primary mediastinal large B-cell lymphoma cells as seen through a microscope.

Primary Mediastinal Large B-Cell Lymphoma (PMBCL)
What is primary mediastinal large B-cell lymphoma (PMBCL)?
Primary mediastinal large B-cell lymphoma (PMBCL) is a rare type of non-Hodgkin lymphoma. Certain white blood cells, called thymic B lymphocytes (or thymic B cells), become abnormal. These cells of the immune system develop in a gland called the thymus. The thymus is located in a space between the lungs called the mediastinum.
PMBCL may spread to nearby organs, such as the lungs or the sac around the heart called the pericardium. The cancer may spread to lymph nodes and distant organs, such as the kidneys.
In pediatric cases, PMBCL is often seen in older teens.
Symptoms of primary mediastinal large B-cell lymphoma
Contact your doctor right away if you notice symptoms such as:
- Trouble breathing
- Cough
- Weight loss
- Fever
- Night sweats
- Fatigue
- Chest pain
- Swelling in the head, neck, or arm
- Loss of appetite
- Feeling light-headed or faint
These symptoms may appear as the tumor grows. The tumor may push on a large vein called the superior vena cava. This vein carries blood from the head, neck, and arms back to the heart. When this happens, it can cause a group of serious problems known as superior vena cava syndrome. This condition needs treatment right away.
Risk factors for primary mediastinal large B-cell lymphoma
Risk factors may increase your child's chances of getting a disease. Little is known about the risk factors for PMBCL in children. For lymphoma, the risk factors we know so far are:
- Weak immune system after a bone marrow or solid organ transplant
- Infection with Epstein-Barr virus or human immunodeficiency virus (HIV)
- A genetic disorder, such as ataxia-telangiectasia, that increases the risk of having cancer
- More common in females than males
- More common in White than Black children
Diagnosis of primary mediastinal large B-cell lymphoma
A cancer diagnosis requires tests and procedures. The doctor will do a physical exam, ask about medical history, and order tests such as:
If the biopsy shows cancer, the lab may do more tests, such as flow cytometry, immunophenotyping, and cytogenetic analysis. The doctor may order genetic tests to find any genetic changes in the cancer cells.
See Waiting for Test Results.
Stages of primary mediastinal large B-cell lymphoma
The care team will plan treatment based on the cancer stage. Some tumors grow rapidly. So, the doctor must stage the lymphoma as quickly as possible.
To find out the stage of the disease, doctors may order more tests such as:
The stage will tell how much cancer is present and if it has spread to other parts of the body.
The International Pediatric Non-Hodgkin Lymphoma Staging System divides the disease into 4 stages:
- Stage 1 and 2 lymphomas are limited-stage disease. The treatment for both stages is similar.
- Stage 3 and 4 lymphomas are advanced-stage disease. PMBCL is always assigned stage 3 or higher. The treatment for both stages 3 and 4 is similar, but the length of treatment may vary depending on the stage.
Treatment of primary mediastinal large B-cell lymphoma
PMBCL can spread quickly, so rapid treatment is needed. Treatment depends on the following:
- Stage of PMBCL
- How well it may respond to treatment
- Available treatments
- Patient age and health
The main treatment for childhood PMBCL is chemotherapy and targeted therapy with rituximab. When possible, patients may have surgery to remove all or part of the tumor. The most common treatments used for PMBCL include DA-EPOCH-R or the Lymphome Malin de Burkitt (LMB) treatment, which includes chemotherapy with rituximab.
Targeted therapies work by acting on, or targeting, specific features of tumor cells. Scientists are testing drugs to see if they can block the signals that cause cancer cells to grow. Your care team may suggest targeted therapy, immunotherapy, bone marrow transplant, or a clinical trial.
Treatment can sometimes cause side effects. One side effect that may occur early in treatment is tumor lysis syndrome. This happens when cancer cells quickly die and break apart. The care team will watch your child closely for possible side effects. Talk to your child’s care team if you have questions.
Relapsed disease
A common chemotherapy plan for relapsed disease is RICE (rituximab, ifosfamide, carboplatin, etoposide) followed by a stem cell transplant. New targeted therapies are being studied. Some patients may be able to take part in clinical trials to test new treatments.
Prognosis for primary mediastinal large B-cell lymphoma
The 4-year overall survival rate for childhood PMBCL is about 85% in the United States.
Support for patients with primary mediastinal large B-cell lymphoma
Coping with a cancer diagnosis and treatment can be stressful. You may want to talk to a social worker, psychologist, or another mental health specialist.
Learn how to talk to your child about cancer.
After treatment, your child's doctor may use imaging tests and exams to watch for recurrence. Childhood cancer survivors should get follow-up care throughout their lives. Some treatments can cause late effects. These are health problems that happen months or years after the end of treatment.
After completing treatment, it is important to:
- Have regular checkups and screenings by a primary care provider
- Maintain healthy habits, including physical activity and healthy eating
- Have a survivorship care plan to share with health providers. This plan should include:
- Guidance on health screenings
- Disease risk factors
- How to improve health
Questions to ask your care team
- What does the biopsy show?
- What stage of cancer does my child have?
- What are my child's treatment options?
- What are the possible side effects of each treatment?
- How does my child manage side effects?
- Will my child need to be in the hospital for treatment?
- Where is the treatment available? Is it close to home or will we have to travel?
- What resources can we use to help cope with this illness?
- What follow-up does my child need after treatment?
- How can I help my child stay healthy?
- What are the possible late effects of treatment?
Key points about primary mediastinal large B-cell lymphoma
- Primary mediastinal large B-cell lymphoma (PMBCL) is a type of non-Hodgkin lymphoma that starts in the B cells in the space between the lungs (mediastinum).
- Doctors may diagnose this cancer using a physical exam, blood tests, imaging, biopsy, and other tests.
- Treatment depends on genetic changes to the cells, stage of cancer, and the patient's health.
- Treatment options may include chemotherapy, immunotherapy, targeted therapy, stem cell transplant, or possibly a clinical trial.
- Each case is different. But the 4-year survival rate in the United States is about 85%. Your doctor is the best source of information about your child's case.
Find out more information
-
Lymphoma
Lymphoma is a cancer of the lymphatic system, which is a network of nodes, glands, and vessels that transports lymphocytes throughout the body.
-
Non-Hodgkin Lymphoma
Non-Hodgkin lymphoma is a cancer of the lymphatic system. There are about 800 new cases diagnosed in U.S. children and teens each year.
-
How to Talk to Your Child about Cancer
Talking to your child about their cancer diagnosis can be a difficult conversation. Work with your health care team to learn the best ways to talk to your child.